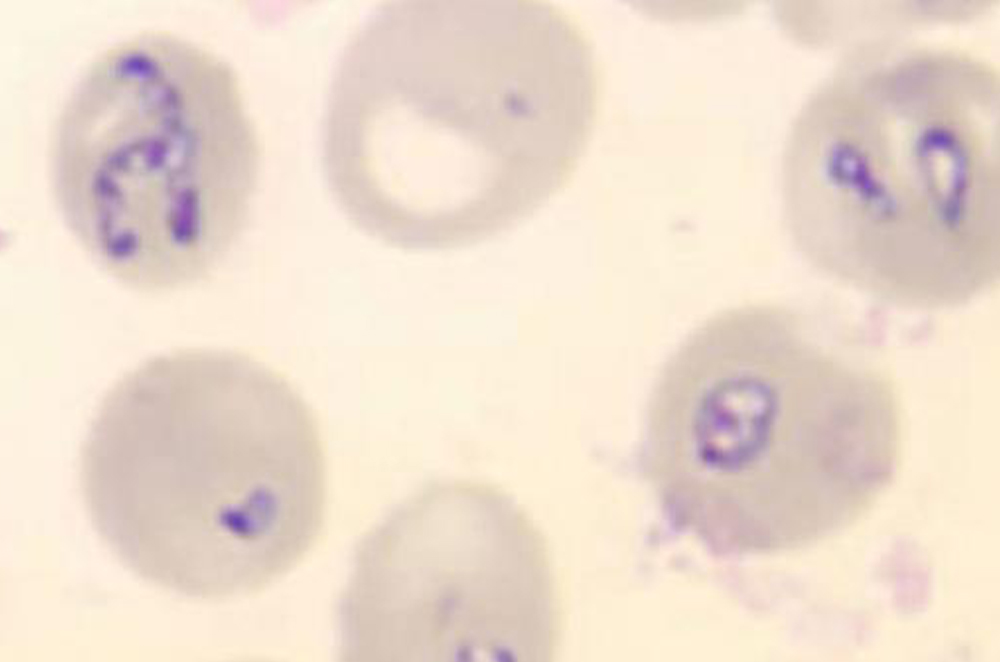

Choroba z Lyme, znana również jako borelioza, jest powodowana przez spiralną bakterię zwaną Borrelia burgdorferi. Jest to najczęściej rozpoznawana choroba przenoszona przez kleszcze. Chociaż choroba znana była od ponad 100 lat, dopiero w 1982 roku Willy Burgdorfer odkrył, że jest ona spowodowana przez bakterie znajdujące się w jelitach kleszczy. Szacuje się, że co roku w Polsce dziesiątki tysięcy osób zakaża się tą chorobą!
Objawy choroby z Lyme są zróżnicowane, a niektóre z nich są podobne do innych chorób. To sprawia, że borelioza jest rozpoznawana przez lekarzy różnych specjalności (w tym np. dermatologów, neurologów). Jednym z najczęstszych objawów boreliozy jest zaczerwienienie wokół miejsca wkłucia kleszcza rozszerzające się obwodowo (tzw. rumień wędrujący). Zaczerwienienie skóry w kształcie pierścienia lub owalnej plamy otaczające miejsce ukłucia przez kleszcza jest często obserwowane w ciągu pierwszych kilku dni do tygodnia1.
Jednak rumień po ukłuciu kleszcza nie występuje u wszystkich pacjentów z boreliozą – dotyka około 40-60% zakażonych. Oprócz zmiany skórnej we wczesnych stadiach boreliozy mogą pojawić się bardziej ogólne objawy, takie jak zmęczenie, zawroty i bóle głowy. Następnie ujawniają się różne inne objawy boreliozy, najczęściej w postaci porażenia nerwu twarzowego, widoczne jako porażenie połowy twarzy. Inne rzadsze symptomy mogą obejmować bóle i problemy z sercem, zapalenie stawu (najczęściej kolanowego), aż po poważne zapalenie opon mózgowo-rdzeniowych.
1. Dunaj J, Moniuszko A et al. Przegląd Epidemiologiczny 2013; 67: 35-39.

Zgodnie z aktualną wiedzą naukową zakażenie boreliozą możliwe jest tylko w wyniku pokłucia przez zakażonego kleszcza. Nie możesz zarazić się boreliozą od osoby, która na nią choruje. W związku z tym, iż Borrelia przebywa w jelicie środkowym kleszcza, zanim bakterie zdążą się przedostać z kleszcza do żywiciela poprzez gruczoły ślinowe, upływa trochę czasu. Nim bakteria dotrze do tkanek gospodarza, może minąć wiele godzin od rozpoczęcia żerowania przez kleszcza. Z tego powodu im szybciej kleszcz zostaje usunięty, tym mniejsze jest ryzyko zakażenia boreliozą1.
21 200 - tyle przypadków choroby stwierdzono w Polsce w 2017 roku
Borelioza występuje na całym świecie, dokładnie wszędzie tam, gdzie są kleszcze. Istnieją różne gatunki kleszczy, które znane są jako nosiciele boreliozy. W Europie to kleszcz pospolity ( Ixodes ricinus) jest najważniejszym winowajcą. Jednak dystrybucja patogenu w populacjach kleszczy jest różna. Możliwe jest również kilkakrotne zakażenie po wcześniejszym wyleczeniu.
Według Państwowego Zakładu Higieny tylko w roku 2017 stwierdzono w Polsce 21 200 przypadków boreliozy. Im dłużej kleszcz pozostaje wkłuty w skórę, tym większe jest ryzyko zakażenia. Nie istnieje szczepienie, które może chronić przed tą chorobą.
Chcesz wiedzieć więcej? Pobierz ulotkę
Niemniej jednak nie każdy, kto ulegnie zakażeniu Borrelią w wyniku pokłucia przez kleszcza, faktycznie zachoruje. W wielu przypadkach organizmowi udaje się wyeliminować bakterie bez leczenia- infekcja nie powoduje żadnych dolegliwości, ani późniejszych skutków. Dlatego możliwe jest wykrycie przeciwciał przeciwko Borrelii nawet we krwi zdrowych osób. Jak pokazują statystyki, do 25% ludzi ma te przeciwciała, nigdy wcześniej nie chorując na boreliozę. Tylko 0,5 do 1,5% osób pokłutych przez kleszcza zachoruje.
1. Zajkowska J. Przegl Epidemiol. 2010; 64(4):525-31.
2. Hofhuis A et al. PLoS ONE 2017; 12(7): e0181807.

Najczęściej obserwowanym objawem choroby związanej z boreliozą dla lekarza jest charakterystyczny rumień po kleszczu, zwany wędrującym, przyjmujący postać rozległego zaczerwienienia w kształcie pączka. Często rozwija się wokół miejsca pokłucia kleszcza, ale może również uwidocznić się na innych częściach ciała. Ponieważ może upłynąć nawet 28 dni, zanim pojawi się charakterystyczna zmiana ostrzegawcza, ważne jest obserwowanie okolic, w które wkłuł się kleszcz.
Gdy pojawi się taki rumień, a pacjent przypomina sobie, że został ukłuty przez kleszcza, lekarz przepisuje odpowiednie antybiotyki w celu leczenia boreliozy. Wykonanie badania boreliozy poprzez przesłanie krwi do laboratorium może być zbędne, ponieważ zwykle nie jest możliwe wykrycie przeciwciał przeciwko bakterii
Borrelia we wczesnych stadiach zakażenia, a wygląd rumienia jest bardzo charakterystyczny. Rozpoznanie choroby z Lyme na późniejszych etapach wiąże się z większymi trudnościami. Rumień zwykle w tym czasie nie jest już widoczny. Wielu pacjentów nie będzie już pamiętać o pokłuciu przez kleszcza, ponieważ upłynie sporo czasu, czasem całe lata od tamtego zdarzenia. Lekarz musi dokładnie zapoznać się z objawami, które pacjent manifestuje – takimi jak zmiany na skórze, dolegliwości korzonkowe, stawowe lub porażenie twarzy – a także rozważyć możliwość wystąpienia innych chorób, które mają podobne objawy.
Pozytywne wyniki badań laboratoryjnych nie zawsze świadczą o zakażeniu bakterią wywołującą boreliozę i wymagają weryfikacji, ponieważ niekiedy prawdziwa przyczyna dolegliwości zostanie przeoczona. Jednak gdy test krwi na przeciwciała bakterii
Borrelia jest ujemny, lekarz prawie na pewno może wykluczyć możliwość wystąpienia choroby z Lyme.

Badania na boreliozę w celach diagnostycznych może zlecić specjalista chorób zakaźnych, ale też neurolog, okulista lub dermatolog, ponieważ choroba atakuje różne organy. W pierwszej kolejnośc wykonuje się badanie serologicznie oznaczające przeciwciała przeciw boreliozie w klasie IgG/IgM, jednak ich obecność na wczesnym etapie nie jest oczywistym dowodem boreliozy, ponieważ często występują one również we krwi osób zdrowych.
Standarem diagnostycznym jest wykonanie wstępnych badań metodą ELISA i potwierdzenie ich testem Western blot. Wynik badania serologicznego zależy od stadium choroby, czasu występowania objawów i ewentualnych terapii antybiotykowych. Pozytywnych wyników badań serologicznych można oczekiwać najwcześniej w 3-4. tygodniu od zakażenia. Tak więc wykonywanie tych badań w kilka dni po kontakcie z kleszczem (np. w okresie wystąpienia rumienia wędrującego) nie ma uzasadnienia. Inaczej jest w przypadku PCT i PCT Real Time – to badania boreliozy, które mają wyższą skuteczność ze względu na wyszukiwanie DNA bakterii, ale wykonuje się je tylko przy szczególnych objawach z wycinków skóry, płynu mózgowo-rdzeniowego lub stawowego.

Borelioza jest spowodowana infekcją bakteryjną, we wczesnym stadium można ją wyleczyć antybiotykami. W przypadkach przewlekłych objawów skutki choroby mogą utrzymywać się dłużej po zakończeniu terapii antybiotykiem. Takie osoby wymagają leczenia wspomagającego lub nawet rehabilitacji1.
.1. John J Halperin. Infection and Drug Resistance 2015:8 119–128.

Najlepszą ochroną przed boreliozą jest unikanie pokłucia przez kleszcza tam, gdzie to możliwe. Dobrze jest także, gdy kleszcze są znajdowane i usuwane natychmiast. W związku z tym, iż ukłucie przez kleszcza nie powoduje bólu, po pobycie wśród natury należy dokładnie obejrzeć całe ciało.
Przyjmowanie antybiotyków jako profilaktyki po pokłuciu przez kleszcze nie jest zalecane. Nie ma też sensu przeprowadzanie badania kleszcza na obecność patogenów.
Nawet jeśli kleszcz zawiera krętki
Borrelia, w niewielu przypadkach prowadzi to do rozwoju objawów choroby. Obecnie nie jest dostępna szczepionka dla ludzi przeciw boreliozie.
1. Hofhuis A et al. PLoS ONE 2017; 12(7): e0181807.

Kleszczowe zapalenie mózgu (KZM) jest chorobą powodowaną przez wirus KZM objawiającą się zapaleniem opon mózgowo-rdzeniowych, zapaleniem mózgu lub jednym i drugim. Może być śmiertelne.
Faktem jest, że kleszcze mogą zawierać wiele patogenów oraz przenosić równie wiele chorób. Czym oprócz wirusa KZM i bakterii Borrelia, może zarazić Cię kleszcz?


Zobacz, czy jesteś w grupie ryzyka zakażenia się kleszczowym zapaleniem mózgu.
Zrób test